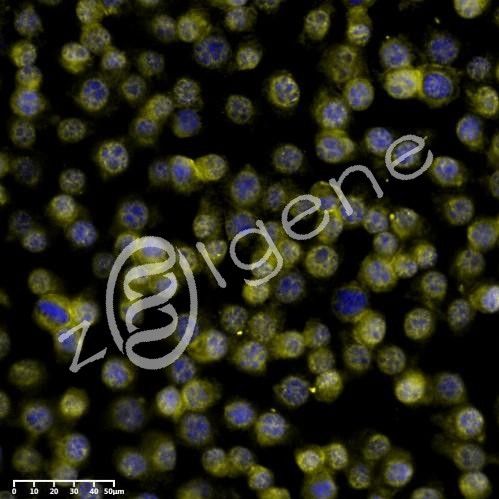
原位杂交(FISH)

搜索到 87 条记录

硬组织切片/骨磨片/骨形态计量分析/特殊染色
一、技术简介 提供制备不脱钙硬组织切磨片服务。硬组织切磨技术具有特殊的技术特点、技术配置和工艺方法,均与软组织病理制片不同。新鲜的不脱钙骨组织(或带有内植物/种植体)标本经过固定及脱水处理后,用树脂浸透、包埋、干燥和聚合,再行切片或和锯片、磨片抛光等步骤,最后制成厚约5μm以上的
地区:北京服务名称:硬组织切磨片 硬组织特殊染色

组织标本处理(取材、脱水、包埋、切片、HE染色、特殊染色、大标本制作)
组织标本基本处理,取材、脱水、包埋、切片、HE染色、特染、大标本制作等。 严谨的态度,精湛的技术,热情的服务——我们追求的理想境界!
原位杂交(FISH)
▶ 产品介绍 原位杂交(fish)是指将特定标记的已知序列核酸为探针与细胞或组织切片中核酸进行杂交,从而对特定核酸顺序进行精确定量定位的过程。 原位杂交可以在细胞标本或组织标本上进行,也可以检测两个靶基因的共定位情况。 ▶ 优势 1.采用进口abcam、CST、Santa、omni
地区:中国提供商:载基生物

肝癌组织芯片(LVC1609)
、RNA 和蛋白质目标提供了靶。同时前后关联的单元可以迅速分析样本部分的几百个分子标记,以及构建未培养的人类肿瘤的相关遗传细胞型或表现型特征数据库。 简介描述肝癌及自体癌旁,80例,160芯(1.5mm),详尽生化指标,带有复发资料,5年生存期肝癌组织芯片,自体癌与癌旁配对,80例
地区:上海服务名称:组织芯片
¥6000-9000

普鲁士蓝染色服务
品牌 其他品牌 产地类别 国产 应用领域 医疗卫生,生物产业,综合 普鲁士蓝染色服务是非常经典的组织化学反应,是显示组织内三价铁的一种敏感、传统优良的方法,其染色原理为:三价铁离子从蛋白质中被稀盐酸分离出来,生成不溶解的蓝色化合物,即普鲁士蓝。 普鲁士蓝染色:又称含铁血黄素染色,
地区:上海服务名称:普鲁士蓝染色服务
询价

碱性磷酸酶染色实验服务
碱性磷酸酶染色实验服务 碱性磷酸酶染色实验技术简介: 碱性磷酸酶(AKP) 的显示方法zui早由Gomeri (1939) 提出,现在这种方法称为Gomeri法。碱性磷酸酶是指磷酸单酯酶I,它能在pH8. 6~10.0的zui适条件下分解磷酸单酯,对于与磷酸相接的醇基没有特异性,
服务名称:碱性磷酸酶染色实验代做提供商:上海研谨生物

标本处理预咨询
长期的研发、推广活动中,我们感到有些病理技术专业以外人士,对处理标本环节注意不够,结果,造成标本的不当处理,固定前、固定中、固定后都有问题出现,饲养的动物模型坏死等异常改变,浪费时间精力,浪费资金。我们可以为您提供预先咨询服务,很好的注意解决这些问题。 严谨的态度,精湛的技术,热

病理学技术服务
病理学技术服务 我们拥有专业的实验室、先进的实验设备和经验丰富的科研技术人员。,主要致力于基因组学、转录组学、蛋白质组学、代谢组学、生物化学、病理检测、基因检测等技术在科研中的应用与推广。通过高度细分、全方位的服务平台,为广大客户提供了完善的技术解决方案和服务。 科研实验服务:
地区:上海服务名称:病理学技术服务

检测实验丨油红O染色实验
油红O染色 油红O染色是一种常用于检测细胞中脂质积累的染色方法,尤其在研究脂肪细胞和肝脏病理学中具有重要应用。该染色方法通过油红O染料与细胞或组织内的脂质滴特异性结合,使脂质在显微镜下呈现出鲜明的红色,从而便于观察和分析。 一、染色原理: 油红O染色的原理基于油红O染料对脂质的亲
地区:天津服务名称:油红O染色实验

组织病理染色
组织病理染色 HE染色 原理: HE(HematoxylinEosin)染色:又称苏木素-伊红染色法,这是是普通光学显微镜观察与鉴别细胞凋亡与细胞坏死的一种染色方法。这种方法适用范围广泛,对组织细胞的各种成分都可着色,便于全面观察组织构造,而且适用于各种固定液固定的材料,染色后不
地区:天津服务名称:组织病理染色
¥100-1000

硬组织切片
异形骨样本 骨样本长度、宽度及内容物不确定,制片价格视具体骨样确定 块 N≤8 张 AY214 冠脉血管(带支架)切片 含不锈钢或镍铬合金等支架材料冠脉血管,制备厚度5-8µm切片 块 N≤8 张 艾佧科技(北京)有限公司位于最具活力的北京市经济技术开发区,是一家专业从事医学软组
地区:全国服务名称:硬组织样本切片

病理切片扫描服务
病理切片扫描是将切片在切片扫描仪的显微镜头下快速移动进行扫描成像并通过控制软件系统无缝拼接生成一整张全视野的数字化切片,该文件包含了组织切片上所有的组织信息。本公司提供针对各种染色,免疫组化,免疫荧光,组织芯片,原位杂交等所有切片数字切片扫描服务。 病理切片扫描的影像系统可以将传
地区:/服务名称:/
询价

病理切片技术服务
石蜡切片是组织学常规制片技术中应用最广的方法。石蜡切片不仅可用于观察正常细胞组织的形态结构,也是病理学等学科用以研究、观察及判断细胞组织的形态变化的主要方法。HE染色法是石蜡切片技术里常用的染色法之一 ,是组织学、胚胎学、病理学教学与科研中基本、使用广泛的技术方法。 菲优特检测可
地区:山东服务名称:病理切片技术服务

病理学检测技术服务
病理学检测技术服务 病理学是研究疾病发生发展中集体的形态,机能和代谢等方面的变化及其规律的科学,为诊断和防治疾病提供必要的理论基础。可进行定性和半定量分析。 项目 价格(元) 说明 石蜡包埋 10/个 普通组织,特殊组织另计 HE染色 20/片 包括所有试剂和耗材 特殊染色 80
地区:上海服务名称:病理学检测技术服务

病理定量/阳性率分析
通过专业的数字切片分析软件,对整张数字病理切片图像进行全面智能分析。其综合了目前数字病理的大部分需求,为病理诊断工作者提供全面的定量分析与可靠的数据支持,尤其在论文发表、学术研究领域提供了量化数据支撑。 分析项目介绍: 1. 常规细胞定量分析,其不限于某几种染色方法,如KI67,
地区:全国服务名称:病理定量/阳性率分析
¥80

电镜
透射电子显微镜(Transmission Electron Microscope,TEM)是使用最为广泛的一类电镜。通过发射电子束从而穿过超薄的样品切片(通常为50~100 nm)相互作用,既而形成图像。透射电镜具有分辨率高和放大倍数高的优点。目前透射电镜已经广泛的应用到癌症研究
地区:全国服务名称:电镜

石蜡切片、冰冻切片
全套的病理技术服务取材、处理、包埋、切片、H&E染色、诊断。 石蜡切片20元/张,冰冻切片50元/张。 石蜡切片(paraffin section)组织学常规制片技术中最为广泛应用的方法。石蜡切片不仅用于观察正常细胞组织的形态结构,也是病理学和法医学等学科用以研究、观察及判断细胞
地区:全国服务名称:病理切片加工

芯片检测
芯片检测 组织芯片(tissue chip),也称组织微阵列(tissue microarrays),是生物芯片技术的一个重要分支,是将许多不同个体组织标本以规则阵列方式排布于同一载体(使用载玻片最多)上,进行同一指标的原位组织学研究,组织芯片技术可以与其他很多常规技术如免疫组织
地区:全国服务名称:芯片检测
询价

特殊染色(威斯腾生物-中关村生物医学研发检测共享平台!)
液体应该由配制液体的人标明最初的日期。 ·使用时要注意防止液体交叉污染 ·用蒸馏水或双蒸馏水配制液体。 ·使用分等级的化学试剂。 ·使用组织技术专家证明合格的染料。 ·随时将装有液体的瓶子塞好。 ·冷藏液体应该倒入染色缸内,在室温下复温染色,液体瓶应该及时放回冰箱。 ·所有染液使用
地区: 全国服务名称:特殊染色

病理服务—TUNEL染色(DAB\荧光)
内注射、技术成熟稳定 12、肾脏缺血、肾移植、肾衰动物模型 肾脏缺血、肾移植、肾衰竭实验及检测平台 注:点击模型名称查看详细信息 检测平台 服务项目 服务承诺 服务周期 样本种类 病理切片、免疫组化 染色结果照片 2-3周 组织 Western blotting 胶片 1-2周 蛋
地区:全国服务名称:病理服务—TUNEL染色(DAB\荧光)

石蜡包埋切片
产品简介: 石蜡切片(paraffin section)组织学常规制片技术中最为广泛应用的方法。石蜡切片不仅用于观察正常细胞组织的形态结构,也是病理学和法医学等学科用以研究、观察及判断细胞组织的形态变化的主要方法,而且也已相当广泛地用于其他许多学科领域的研究中。 公司简介: 深圳
地区:深圳服务名称:石蜡包埋切片

包埋、切片、爬片
MDL-百奥思科可以提供组织石蜡包埋与樱花包埋服务、硬组织脱钙或者硬组织直接切片和细胞样品的爬片制备等各种病理学检测服务。 普通包埋 经固定后的组织 特殊包埋 细胞、眼球、材料等 石蜡切片 蜡头 樱花包埋 新鲜组织 冰冻切片 固定组织、新鲜组织 芯片切片 蜡头 脱钙 固定后的组织
地区:全国服务名称:包埋、切片、爬片





